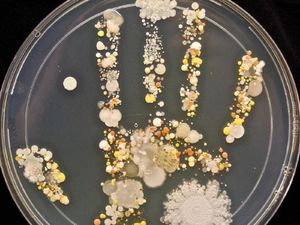
Foto-Foto Cantik Ini Tunjukkan Penampakan Koloni Bakteri di Tangan Foto-Foto Cantik Ini Tunjukkan Penampakan Koloni Bakteri di Tangan

detikHealthSabtu, 09 Okt 2021 21:14 WIB
detikHealthSabtu, 09 Okt 2021 21:14 WIB
Chicco Jerikho Sempat Kritis karena Sepsis, Ini Kemungkinan Penyebabnya
Aktor Chicco Jerikho bercerita pengalaman saat dirinya kritis di rumah sakit karena sepsis. Kondisi ini bisa disebabkan oleh berbagai hal.